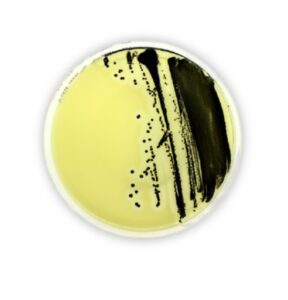
Chromatic

Promoción especial
Seguridad alimentaria
Ponemos a su alcance toda una gama de productos para el control y el mantenimiento de la seguridad alimentaria: Bolsas para recoger, transportar y analizar a muestras, portaobjetos de agar, placas de contacto, indicadores biológicos… Descubra a continuación esta selección de productos y no dude en solicitarnos más información o presupuesto.